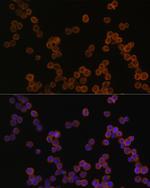
CD44 Antibody in Immunocytochemistry (ICC/IF)

Search
Bioss
CD44 Polyclonal Antibody
{{$productOrderCtrl.translations['antibody.pdp.commerceCard.promotion.promotions']}}
{{$productOrderCtrl.translations['antibody.pdp.commerceCard.promotion.viewpromo']}}
{{$productOrderCtrl.translations['antibody.pdp.commerceCard.promotion.promocode']}}: {{promo.promoCode}} {{promo.promoTitle}} {{promo.promoDescription}}. {{$productOrderCtrl.translations['antibody.pdp.commerceCard.promotion.learnmore']}}
图: 1 / 8
CD44 Antibody (BS-55039R) in ICC/IF

产品信息
BS-55039R
种属反应
宿主/亚型
分类
类型
抗原
偶联物
形式
浓度
规格
纯化类型
保存液
内含物
保存条件
运输条件
靶标信息
CD44 cell surface antigen is a 100 kDa type 1 transmembrane glycoprotein widely expressed on human leucocytes, white matter of the brain and by some epithelial cells of the intestine and breast. Several isoforms of CD44 exist, including the predominant CD44H isoform detected in many normal tissues. CD44 is a receptor for hyaluronic acid (HA) and is involved in cell-cell interactions, cell adhesion and migration. CD44 also participates in a wide variety of cellular functions including lymphocyte activation, recirculation and homing. CD44 expression may be up-regulated upon some carcinomas, and it has been speculated that this may be related to metastatic potential. CD44 is expressed by hematopoietic, non-hematopoietic cells, epithelial tissues, and to filopodia in cultured keratinocytes. Further, bone marrow myeloid cells and memory T cells express CD44 at high levels, and peripheral B and T cells can upregulate the expression of CD44 in response to certain stimulatory events. Transcripts for the CD44 gene undergo complex alternative splicing that results in many functionally distinct isoforms, however, the full-length nature of some of these variants have not been determined. Alternative splicing is the basis for the structural and functional diversity of the CD44 protein. Diseases associated with CD44 dysfunction include superficial keratitis and lichen sclerosus. CD44 also may be related to tumor metastasis formation.
仅用于科研。不用于诊断过程。未经明确授权不得转售。
篇参考文献 (0)
生物信息学
蛋白别名: CD44; CD44 antigen; CD44 molecule; CD44 molecule (Indian blood group); CD44R1; CDw44; CDw44 antigen precursor; cell surface glycoprotein CD44; Cell surface glycoprotein CD44 (hyaluronate binding protein); cell-cell and cell-matrix adhesion interaction glycoprotein isoform; cell-surface glycoprotein; chondroitin sulfate proteoglycan 8; ECMR-III; ECMRIII; Epican; Extracellular matrix receptor III; GP90 lymphocyte homing/adhesion receptor; hematopoietic cell E- and L-selectin ligand; Heparan sulfate proteoglycan; Hermes antigen; Hermes antigen gp90 homing receptor precursor; homing cell adhesion molecule; homing function and Indian blood group system; homing receptor; HUTCH-I; hyaluronan receptor; hyaluronan-binding protein; Hyaluronate receptor; In(Lu) related-p80; Indian blood group antigen; Ly-24; Lymphocyte antigen 24; PGP I; PGP-1; PGP-I; PGPI; phagocyte glycoprotein 1; Phagocytic glycoprotein 1; Phagocytic glycoprotein I; sCD 44; sCD44; soluble CD 44; soluble CD44; unnamed protein product
基因别名: AU023126; AW121933; AW146109; CD44; CD44A; CDW44; CSPG8; ECM-III; ECMR-III; H-CAM; HCELL; HERMES; Hermes-1; HUTCH-1; HUTCH-I; LHR; Ly-24; MC56; MDU2; MDU3; METAA; MIC4; Pgp-1; Pgp1; RHAMM
UniProt ID: (Human) P16070, (Mouse) P15379, (Rat) P26051
Entrez Gene ID: (Human) 960, (Mouse) 12505, (Rat) 25406




